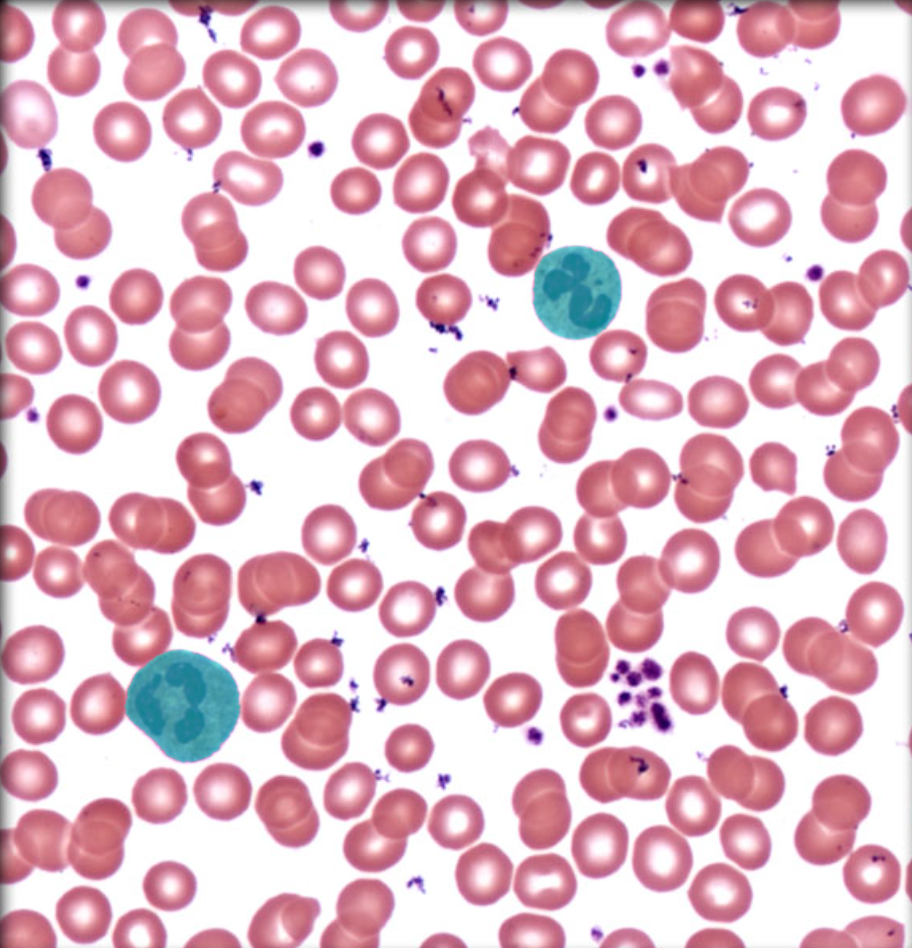
knowt flashcard image
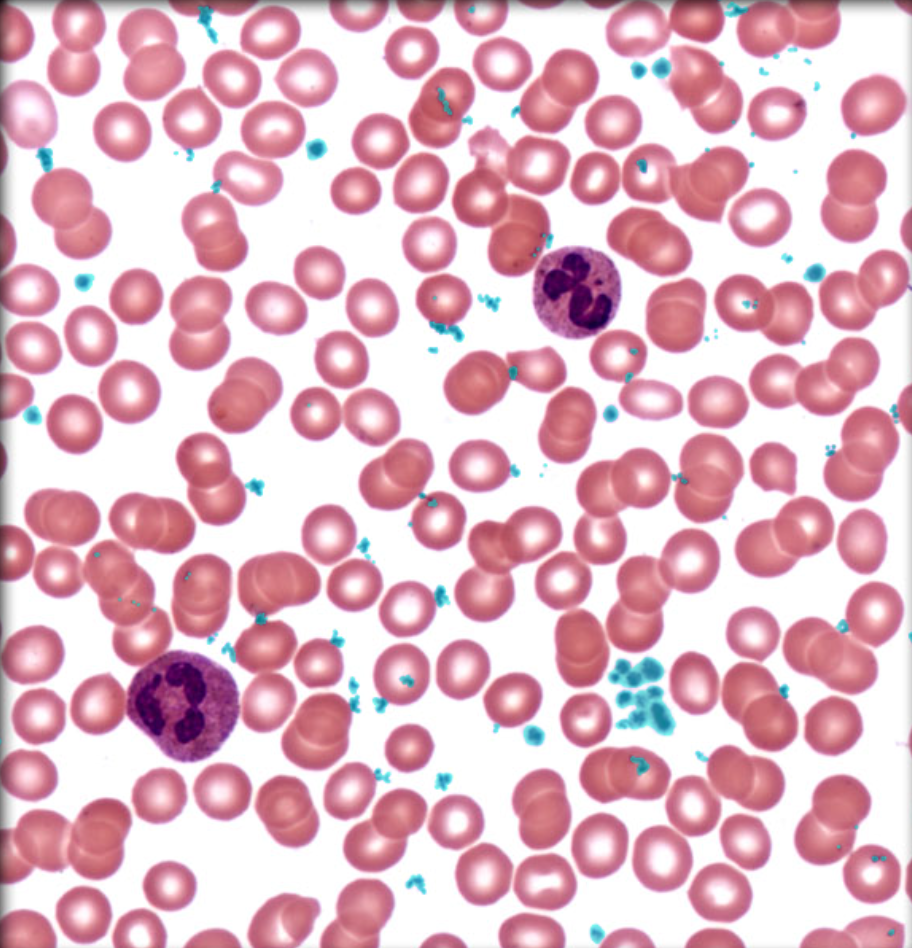
knowt flashcard image

1/53
Looks like no tags are added yet.
Name | Mastery | Learn | Test | Matching | Spaced |
|---|
No study sessions yet.
hypothalamus

Infundibulum of pituitary gland

Pineal gland

Pituitary gland

Anterior pituitary

Posterior pituitary

isthmus of thyroid gland

Thyroid gland

Follicular colloid of thyroid gland

Nucleus of follicular cell of thyroid gland

Parafollicular cell of thyroid gland

Thyroid follicle

Pancreas

Kidney

Spleen

Suprarenal gland

Thyroid gland

Exocrine pancreas

Pancreatic islet of Langerhans

Capsule of suprarenal gland

Suprarenal cortex

Suprarenal medulla

Zona fasciculata

Zona glomerulosa

Zona reticularis

Erythrocyte

Neutrophil
Platelet
Eosinophil

Neutrophil

Basophil

Lymphocyte

Monocyte

Cisterna chyli

Thoracic duct

Remnant of thymus

Splenic a.

Splenic v.

red pulp of spleen

white pulp of spleen

Cortex of lymph node

Lymph node

Medulla of lymph node

Lingual tonsil

Palatine tonsil

Pharyngeal tonsil

Lymphoid nodule of tonsil
